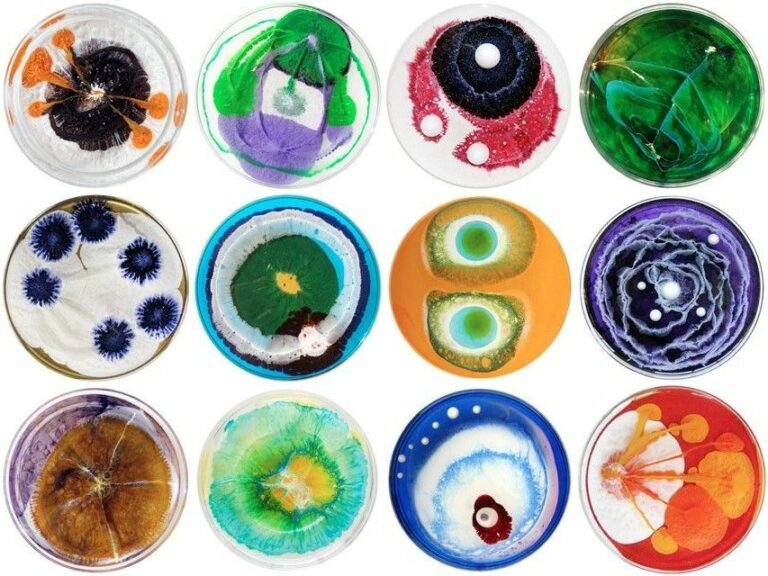
Microbial Creativity: A beautiful fusion between science and art!

Most of us might have heard about the Tesla electric car, manufactured by the Tesla company, and might have thought it as the invention by the 19th-century scientist Nikola Tesla. But the Tesla Company was founded to honor the legendary scientist, more than sixty years after the death of the genius. Tesla was a great scientist whose inventions like Alternating current (AC), a three-phase electric power transmission system, hydro-electric power plant, and electrical transformer, are still in use in one way or another.
Early Life
Based in Smiljan, a small town of the former Austrian Empire, and in modern-day Croatia, Tesla was born on July 10, 1856. He had four other siblings―Dane, Milka, Angelina, and Marica. His mother, Djuka Mandic, although she was a housewife, but was the person who instilled the quest for inventions in the young genius, while he was growing up, through her own small devices for use in the household, during her leisure time.
Tesla’s father, Milutin Tesla, was an orthodox priest and writer in Serbia. He tried to push the young boy to join the priesthood. But the young Tesla had an interest only in the sciences.

Career
As the young boy grew older, he showed signs of remarkable imagination and ingenious creativity. He started his study for a career in engineering at the Technical University at Graz, Austria. At Graz, he saw many scientific instruments, such as Gramme Dynamo, a generator, which spurred Tesla to conceive ideas, which he later on applied to develop Alternating current motor. During his stay at the University of Prague, he witnessed many other applications which instilled the juices of creativity in the young mind for his future inventions.
Eddison-Tesla Partnership
In 1884, Nikola Tesla left Europe and set sail for America with little more than clothes on his back and a letter of recommendation to a famous scientific and business mogul Thomas Edison.
Edison hired Tesla in his well-established company, which manufactured DC-based electronics systems and their distribution in the United States and had become a standard. That kickstarted a short journey of scientific collaboration between the two remarkably genius, yet incompatible personalities. The two scientists began working together and made modifications and improvements to Edison’s inventions, but it lasted only in a few months and they parted their ways.
Tesla’s Solo Career as an Inventor
While Edison was a dominant figure with more focus on business strategies and marketing skills and therefore had financial success, Tesla was a simple man with very little know-how and interest in commercial strategy.
Tesla strived to kickstart his solo career and cast around for investors to convert his tentative plans into practical applications. In 1885, he was able to get funding for the Tesla Electric Light Company and started working on to develop an improved arc lighting, and became successful. Unfortunately, he was once again abandoned by his investors and forced out of the joint venture. For a long time, Tesla had to survive by earning his bread through manual labor jobs. Fortunately, he succeeded in getting some funding for his new Tesla Electric company.

Obstacles
Tesla, throughout his career, discovered, designed, and invented ideas for numerous inventions. Unfortunately, most of his ideas, including the dynamos (a generator which worked like batteries) and induction motors, were stolen and officially patented by other inventors. Despite these hardships, throughout his career, Tesla was a pioneer for the discovery of radar technology, X-ray technology, remote control.
He used the AC principle to develope a rotating magnetic field. His most well-known contributions are the Tesla coil and the AC system, which eventually became dominant in the US, and later on, declared as a standardized electric system all over the world. Tesla’s invention caught the attention of an engineer and businessman George Westinghouse, whose company, Westinghouse Corporation, bought the patent for sixty thousand dollars cash and stocks in Westinghouse Corporation.
Remarkable Inventions
In 1895, Tesla designed the first-ever hydro-electric power plant in the United States at the Niagara Falls. This discovery revolutionized the power generation and helped in rapid industrialization powered by cheap electric power.
Tesla invented another remarkable device that would revolutionize the communications systems forever by the end of the 19th century. He developed Tesla coils and laid the foundations for wireless networks, which are still used even today in several radio technologies and wireless radio transmission antennas.
In the early 20th century, Tesla became obsessed with wireless transmission of energy. Around 1900 he began work on one of his bravest but riskiest projects yet: to build a global wireless communication system to transmit information and providing free energy throughout the world utilizing massive electrical towers.

He started his work by securing funding from a group of prominent investors. However, doubts arose among the investors after a few years of stagnant research with no great achievement. Consequently, Nikola had no choice but to abandon the project and eventually became bankrupt. The staff at his laboratories at Wardenclyffe on Long Island New York was laid off, and the massive tower dismantled and sold for scrap.
Tesla’s legacy
Tesla suffered a nervous breakdown after the failure of this project. His ideas became more and more impractical, and he became an eccentric person spending most of his time with wild pigeons at New York Park.
Miserable and antisocial Tesla spent the last years of his life suffering from a coronary thrombosis and died on January 7, 1947, at the age of 86.
However, Tesla’s legacy remains alive with Hollywood movies made in his honor. A street corner identifying “Nikola Tesla Corner” was installed at the site of his former New York City laboratory.
In 2003, a few engineers founded Tesla Motors, a company in the name of Nikola Tesla, in his Memoriam, intending to develop the world’s first fully electric-powered car.